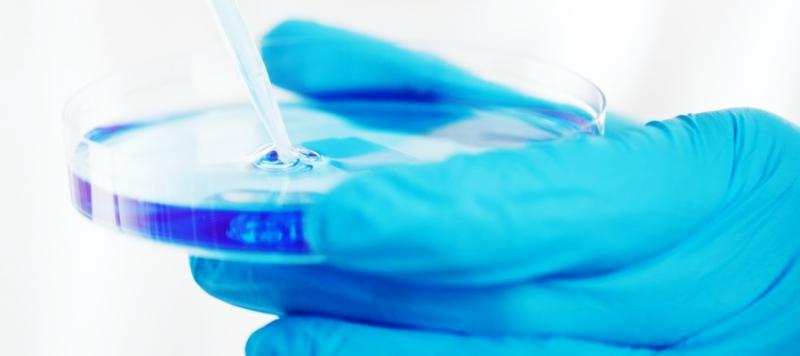
seguridad alimentaria

La Asociación Española de Normalización, UNE, ha publicado la Parte 3 de la norma UNE-EN ISO 16140, que establece el protocolo para la verificación en un único laboratorio de métodos de referencia y de métodos alternativos validados (ISO 16140-3:2021).
UNE-EN ISO 16140 -3
La norma UNE-EN-ISO 16140 especifica diferentes procedimientos de validación de métodos alternativos utilizados en la microbiología de la cadena alimentaria. Estos métodos suelen ser más rápidos, baratos y fáciles de utilizar que los métodos normalizados correspondientes, aunque igualmente eficaces para determinados propósitos.
Pero, para obtener resultados fiables con un método específico y poder comparar los resultados obtenidos con el mismo método en diferentes laboratorios, es necesario que los métodos estén validados con un protocolo común.
La norma UNE-EN-ISO 16140 consta de seis partes:
Parte 1: Vocabulario
Parte 2: Protocolo para la validación de métodos alternativos (registrados) frente a los métodos de referencia.
Parte 3: Protocolo para la verificación de métodos de referencia y métodos alternativos validados, implementados en un único laboratorio
Parte 4: Protocolo para la validación del método en un único laboratorio (interno)
Parte 5: Protocolo para la validación factorial entre laboratorios de métodos no registrados
Parte 6: Protocolo para la validación de métodos alternativos (registrados) para la confirmación y el tipificado microbiologico
De las cuales, la Asociación Española de Normalización, UNE, acaba de publicar la Parte 3: Protocolo para la verificación en un único laboratorio de métodos de referencia y de métodos alternativos validados (ISO 16140-3:2021).
Este documento especifica el protocolo para la verificación de métodos de referencia y métodos alternativos validados para su implementación en el laboratorio usuario.
Ámbito de aplicación
La norma es aplicacble a la verificació de métodos utilizados para el análisis (detección y/o cuantificación), confirmación y tipificación de microorganismos presentes en:
- productos destinados al consumo humano
- productos destinados a la alimentación animal
- muestras ambientales recogidas de las áreas de producción y manipulación de productos alimentarios para consumo humano o animal
- muestras procedentes de la etapa de producción primaria.
El documento es aplicable, en particular, a bacterias y hongos, aunque algunos capítulos pueden ser aplicables a otros (micro)organismos y sus metabolitos, que se determinan según cada caso.
Contenido de la norma
Prólogo europeo
Declaración
Prólogo
Introducción
La serie de Normas ISO 16140
Verificación frente a validación
1 Objeto y campo de aplicación
2 Normas para consulta
3 Términos y definiciones
4 Principios generales de verificación de métodos cualitativos (detección) y métodos cuantitativos
4.1 Generalidades
4.2 Verificación de la implementación
4.3 Verificación de artículos (alimentos)
4.4 Requisitos para la verificación de la implementación y verificación de artículos (alimentos)
4.5 Características de rendimiento
5 Métodos cualitativos. Protocolo técnico para la verificación
5.1 Determinación del LOD 50 estimado (eLOD 50 )
5.2 Diseño experimental
5.3 Selección de artículos (alimentos)
5.4 Contaminación artificial
5.4.1 Selección de cepas
5.4.2 Inoculación de porciones para análisis
5.5 Evaluación de resultados
5.5.1 Determinación de eLOD 50 utilizando el protocolo 1
5.5.2 Determinación de eLOD 50 utilizando el protocolo 2
5.5.3 Uso del protocolo 3
5.6 Límites de aceptabilidad
5.7 Análisis de las causas.
6 Métodos cuantitativos. Protocolo técnico de verificación
6.1 Determinación de la desviación estándar de la reproducibilidad intralaboratorio
6.1.1 Generalidades
6.1.2 Diseño experimental
6.1.3 Selección del artículo (alimento)
6.1.4 Contaminación natural
6.1.5 Contaminación artificial
6.1.6 Evaluación de resultados
6.1.7 Límite de aceptabilidad
6.1.8 Análisis de las causas
6.2 Determinación de la desviación estimada (eBias)
6.2.1 Generalidades
6.2.2 Diseño experimental
6.2.3 Selección de artículos (alimentos)
6.2.4 Contaminación artificial6.2.5
6.2.5 Evaluación de resultados
6.2.6 Límite de aceptabilidad
6.2.7 Análisis de las causas
7 Métodos alternativos validados de confirmación y tipaje. Protocolo de verificación técnica
7.1 Generalidades
7.2 Verificación de la implementación
7.3 Diseño experimental
7.3.1 Generalidades
7.3.2 Selección de cepas
7.4 Evaluación de resultados
7.5 Límite de aceptabilidad
7.6 Análisis de causa principal
8 Resumen de los límites de aceptabilidad aplicables a la verificación de métodos validados
Anexo A (Informativo) Clasificación de categorías (alimentos) y combinaciones objeto de estudio sugeridas para estudios de verificación
Anexo B (Informativo) Recomendaciones sobre cómo elegir un artículo(s) (alimento(s)) difícil(es) para la verificación de artículos (alimentos)
Anexo C (Informativo) Verificación del método cualitativo. Ejemplo
Anexo D (Informativo) Verificación del método cuantitativo. Ejemplo
Anexo E (Informativo) Verificación del método alternativo validado de confirmación o tipaje. Ejemplos
Anexo F (Normativo) Protocolo para la verificación en un solo laboratorio de métodos de referencia no validados
Bibliografía
Fuente: www.une.org/